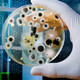
Bacteria communicate 1

-
Pasteur was the first to realize that tiny "bugs" make us sick, and discovered that by infecting the chickens with a weakened or dead strain of cholera, the chicken would not be infected later with the disease. This, he called immunization, and worked to create and discover more vaccines.
Pasteur also discovered that when a liquid or food item is heated to high temperatures and then cooled very quickly, the microorganisms are killed. This process, pasteurization, is still widely used today. -
Promoted sterile surgery: antiseptics, wash hands, gloves sterilize equipment, etc. He also developed antiseptics to clean equipment of microorganisms and taught his students to also use safe surgery practices. His practices became must-have in controling the spread of disease in medicine.
-
Germs that may cause one disease may cure another. They isolated bacillus pyocyanase bacteria and found that it killed other harmful dieases like cholera, anthrax, and typhoid. They created a medication called Pyocyanase, which was the first antibiotic drug used in hospitals.
-
While growing colonies of bacteria in a petri dish, Flemming noticed a strange blu-green mold growing among the samples. No bacteria grew around the mold. The more the mold spread, the more bacteria were killed. Flemming had discovered penicillin, which was an immense breakthrough in antibiotics.
-
Discovered the first commercially available antibiotic, Prontosil, which was the first of a line of drugs called sulfa drugs. These drugs were more powerful in penicillin, and could cure pneumonia, scarlet fever, and other more serious diseases.
-
Although penicillin was discovered in 1928, Florey, Chain, and Pasteur unlocked the true potential of the drug in the 1940's through experiments on mice and rabbits. Chain and Florey began large production of penicillin, and helped expand the business of antibiotic production in regards to penicillin.
-
First bacterium which was found to have resistance to penicillin.
-
Discovered streptomycin, a bacteria found in soil, which proved to be effective in fighting many kinds of intestinal diseases. He created nearly 20 different, new antibiotics, which makes his contribution to the field very large. Also coined the term "antibiotic"
-
Createdthe first antibiotic made by chemically modifying a naturally-produced drug. This drug, Tetracycline, has been one of the most frequently prescribed antibiotics in the United States for treating bacterial infections for several decades.
-
Later became GlaxoSmithKline. Large pharmaceutical company that first mass produced amoxycillin, but as since expanded to being the 4th largest pharmacutical manufacturer in the world. They now own over 17 medical brands.
A list shows items. A timeline shows sequence.
Use Timetoast to make dates, milestones, and turning points easier to understand in a clear visual format. Timetoast is a timeline maker for work, school, research, and stories.